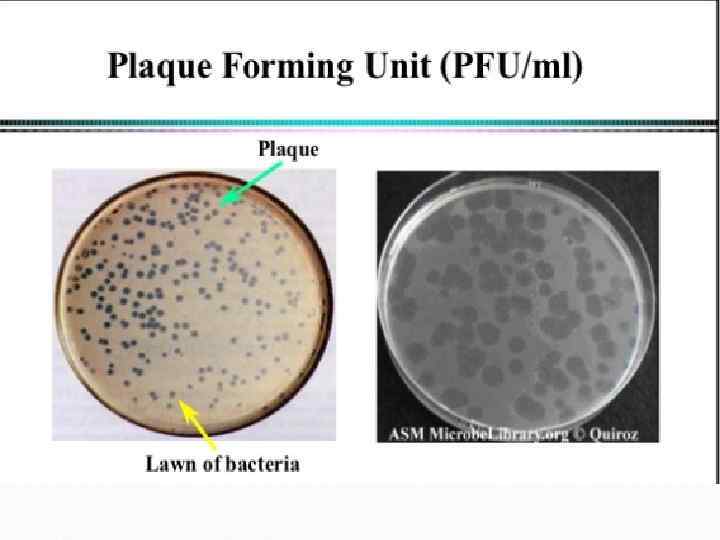
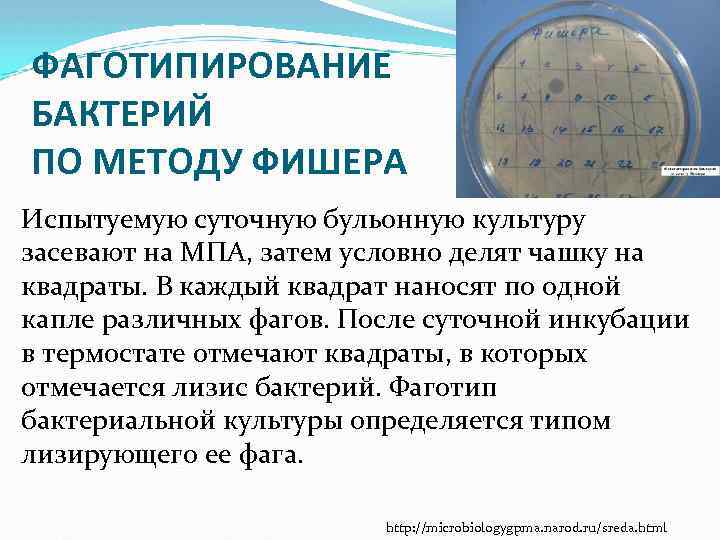
ФАГОТИПИРОВАНИЕ БАКТЕРИЙ ПО МЕТОДУ ФИШЕРА Испытуемую суточную бульонную культуру засевают на МПА, затем условно
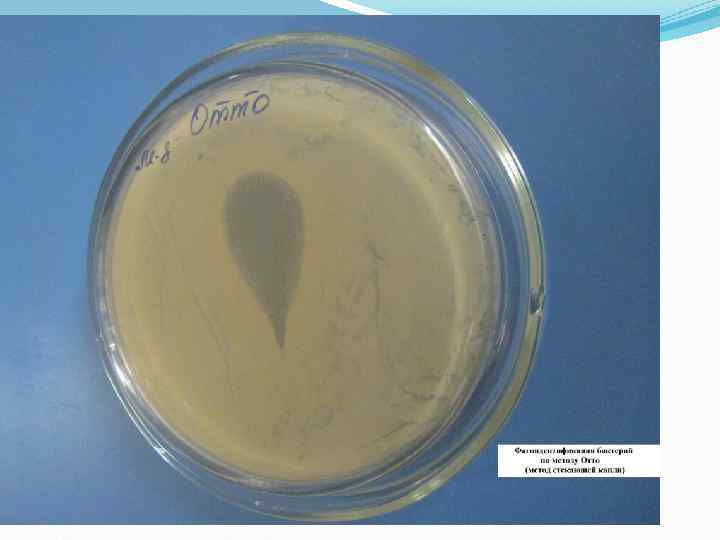
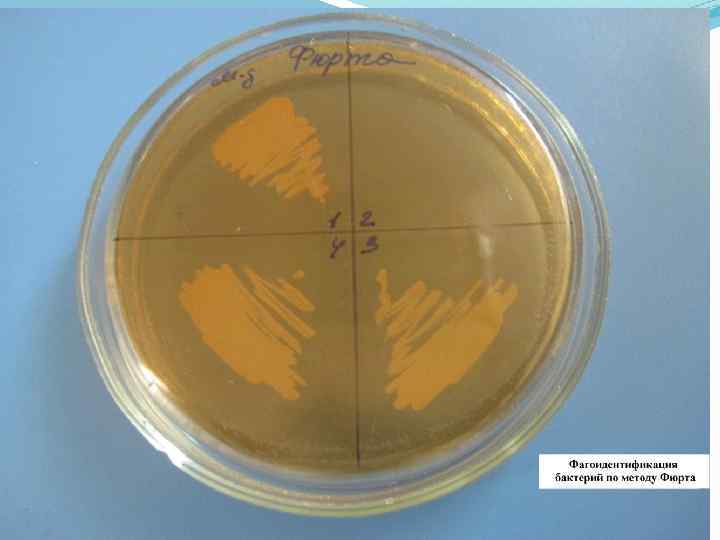

4-Бактериофаги.ppt
- Количество слайдов: 126
![Вирусы бактерий (фаги) [ «бактериофаги» ] Рисунки для презентаций (Ссылка: Internet < 2008 г. Вирусы бактерий (фаги) [ «бактериофаги» ] Рисунки для презентаций (Ссылка: Internet < 2008 г.](https://present5.com/presentation/-57878071_367462995/image-1.jpg)
Вирусы бактерий (фаги) [ «бактериофаги» ] Рисунки для презентаций (Ссылка: Internet < 2008 г. )



http: //www. slideshare. net/josemanuel 7160/tema-16 -microbiologa

http: //www. slideshare. net/Jolie 11/bacteria-viruses#btn. Last

Бактериофаг Т 4

История В древние времена заметили возможность лечения некоторыми речными водами ряда инфекционных заболеваний (проказы и др. ). Фаги обнаружены в 1915 году британским микробиологом Феликсом Twort, и независимо от него в 1917 году франкоканадским микробиологом Феликсом d'Herelle. Twort не изучал фаги, в то время как d'Herelle исследовал природу бактериофагов и возможность их применения в терапии. http: //www. slideshare. net/Fa. To. Oo. Maa/phage-therapy-6802754


http: //www. slideshare. net/josemanuel 7160/tema-16 -microbiologa


http: //www. slideshare. net/josemanuel 7160/tema-16 -microbiologa

Негативные колонии бактериофага средней величины. Увел. 1: 1.

СТРОЕНИЕ фагов


Diagram of bacteriophage structure

Размеры вирусов колеблются 300 нм. от 20 до В среднем они в 50 раз меньше бактерий. Их нельзя увидеть в световой микроскоп, так как их длины меньше длины световой волны.


Бактериофаги


Разные фаги пятого морфологического типа, частица состоит из головки и длинного отростка чехол которого не способен сокращаться. 1, 2 - увел. X 225 000, 3 - увел. X 250 000


A colored electron micrograph of multiple bacteriophages


Генетика бактериофагов ss. RNA, ds. RNA, ss. DNA, ds. DNA ('ss-‘ - single-strand /= одноцепочечный/ 'ds-' - double-strand /= двухцепочечный /) * НК круговые или линейные

-… Типы взаимодействия вирусов с клеткой 1) Вирулентный (литический) тип 2) Умеренный (лизогенный) тип (вирус встраивается в геном /провирус/). Трансдукция. Лизогения (ВПГ, ЦМВ). Лизогенная конверсия. Большинство бактерий полилизогенны. 3) Абортивный тип (без потомства) Непермиссивные клетки.

Внедрение фага в геном бактериальной клетки

http: //www. slideshare. net/Jolie 11/bacteria-viruses#btn. Last

http: //www. slideshare. net/Fa. To. Oo. Maa/phage-therapy-6802754


http: //www. slideshare. net/doctorrao/bacteriophage-11454471



Размножение фагов За один цикл в среднем в клетке появляется 200 дочерних фагов, за второй – 40 000, за 3 -ий – 8 млн и т. д.

http: //www. molbiol. ru/pictures/list_bioche m. html

Бактериофаги

An electron micrograph of bacteriophages attached to a bacterial cell. These viruses are the size and shape of coliphage T 1


Литический цикл Лизогенный цикл


http: //www. slideshare. net/Jolie 11/bacteria-viruses#btn. Last

http: //www. slideshare. net/josemanuel 7160/tema-16 -microbiologa

Фаги второго морфологического типа, частица состоит из одной головки. Увел. X 600 000.

Лизогения сожительство фага с бактерией.

Лизогенная конверсия - Изменение фенотипа бактерий в присутствии профага (например, снижение проницаемости бактерии для иных фагов) - Рост патогенности бактерий

Примеры (лизогенной конверсии) Дифтерийная палочка + фаг β с toх+ геном Токсигенные свойства Холерный вибрион + фаг с tox+ геном - Токсичный штамм. Clostridium botulinum вызывает ботулизм. Streptococcus pyogenes вызывает скарлатину эритрогенным токсином.

+ Шига токсина Столбняк Кишечная палочка + фаг ЭГКП (tox+)

Титрование по Аппельману Фаготипирование бактерий

ФАГОИДЕНТИФИКАЦИЯ БАКТЕРИЙ ПО МЕТОДУ ОТТО (МЕТОД СТЕКАЮЩЕЙ КАПЛИ) На чашку с МПА шпателем выполняется посев суточной бульонной культуры бактерий. Затем наносят каплю известного бактериофага и, наклонив чашку, дают капле несколько растечься по поверхности питательной среды. Через сутки наблюдают полную задержку роста в месте внесения диагностического фага. http: //microbiologygpma. narod. ru/sreda. html
ФАГОТИПИРОВАНИЕ БАКТЕРИЙ ПО МЕТОДУ ФИШЕРА Испытуемую суточную бульонную культуру засевают на МПА, затем условно делят чашку на квадраты. В каждый квадрат наносят по одной капле различных фагов. После суточной инкубации в термостате отмечают квадраты, в которых отмечается лизис бактерий. Фаготип бактериальной культуры определяется типом лизирующего ее фага. http: //microbiologygpma. narod. ru/sreda. html

ФАГОИДЕНТИФИКАЦИЯ БАКТЕРИЙ ПО МЕТОДУ ФЮРТА В расплавленный и остуженный МПА (4550 гр. С) добавляют определенный бактериофаг и выливают в чашку Петри. Чашка с полученным агаром делится на несколько секторов, в каждый из которых засеваются неизвестные культуры, выделенные от больных. Там, где культура соответствует бактериофагу, наблюдается отсутствие роста (лизис) бактерий. http: //microbiologygpma. narod. ru/sreda. html

ТИТРОВАНИЕ БАКТЕРИОФАГА ПО МЕТОДУ ГРАЦИА 1, 0 мл фага смешивают в пробирке с 0, 5 мл бактериальной культуры и добавляют в эту же пробирку расплавленный МПА. Все содержимое выливают в чашку с МПА. Дают застыть верхнему тонкому слою и ставят в термостат. При встрече фага с бактерией, происходит лизис последней и образуется негативная колония фага. Такие негативные колонии затем подсчитывают для определения титра. Титром фага называют количество фаговых частиц в 1 мл препарата фага. http: //microbiologygpma. narod. ru/sreda. html

Классификация фагов Изучено (электронной микроскопией ) более 5000 фагов. Фаги разделяют на 13 семейств

Фаги Полифаги Монофаги (противочумный) Типовые фаги -- У золотистого стафилококка 23 фаготипа -- У сальмонелл тифи 78 фаготипов


Преимущества Фаги размножаются только в присутствии бактерий, и умирают в их отсутствии Не вызывает аллергии Не влияют на естественную иммунную систему организма Высокий химиотерапевтический индекс Поддержка нормофлоры

+ Действуют быстрее и эффективнее /? /, чем обычные антибиотики. Имеют достаточно длительный срок хранения (до 2 лет). Низкие затраты на производство фагов. http: //www. slideshare. net/Fa. To. Oo. Maa/phage-therapy-6802754

Недостатки Хранение в холодильнике. /? / Высокая специфичность Если этиология неизвестна или возбудителей несколько, то применение проблематично. До лечения необходимо определение чувствительности к фагам (т. е. фаги менее пригодны для острых случаев). http: //www. slideshare. net/Fa. To. Oo. Maa/phage-therapy-6802754


Применение фагов

Применение фагов в медицине и эпидемиологии - Профилактика ВБИ (смешанные бактериофаги) - Лечение (дисбактериоза, сепсиса. . . ) - В эпидемиологии. Если 2 фаготипа сальмонелл, то надо искать 2 источника заражения. - Диагностика инфекций (фагодиагностика по Фишеру, по Отто) - Для обнаружения бактерий в материале (РНТФ – реакция нарастания титра фагов)

- В ветеринарии - Пищевые добавки в с/х - Для уничтожения листерий в пищевых продуктах (сыре, мясе, салатах)

- Для ускорения регенерации тканей - Для профилактики зб - В генной инженерии -- Для передачи и распространения нужных генов (лечение смертельных генетических зб) -- Для клонирования нужных генов

- В лечении бактериальных инфекций Например, ларингит, инфекции кожи, дизентерия, конъюнктивит, пародонтит, гингивит, синусит, инфекции мочевыводящих путей и кишечные инфекции, ожоги, фурункулез, полимикробноые биопленки на старых ранах, язвы и инфицированные хирургические раны (фаг на раны). http: //www. slideshare. net/Fa. To. Oo. Maa/phage-therapy-6802754

http: //www. slideshare. net/Fa. To. Oo. Maa/phage-therapy-6802754

http: //www. slideshare. net/Fa. To. Oo. Maa/phage-therapy-6802754

http: //www. slideshare. net/Fa. To. Oo. Maa/phage-therapy-6802754

Предполагаемые области применения Лечение онкологических зб Лечение бактериальных инфекций НС (фаги проникают через ГЭБ) Лечение лиц с множественной лекарственной устойчивостью бактерий. Котерапевтическое средство для лечения (фаги + а/б) Биоконтроль инфекций http: //www. slideshare. net/Fa. To. Oo. Maa/phage-therapy-6802754


Титрование по Аппельману (определение титра фагов) 1. Раститровка фагов по питательной среде для бактерии 2. + по капле суспензии бактерий в каждую пробирку 3. 37 градусов на 8 -12 часов Последняя прозрачная пробирка (где «за ночь» фаги успели убить бактерии) считается титром фагов.

"Воображение важнее, чем знание. " Мы получили знания. Теперь все, что нам нужно сделать, это представить себе возможности.

http: //www. slideshare. net/Fa. To. Oo. Maa/phage-therapy-6802754

Занятие по генетике Титрование бактериофагов по Аппельману Фагодиагностика по Фишеру и Отто Виды изменчивости Оперон (Э, С, промоторы) Эпигенетика Генодиагностика (ПЦР, метод «отпечатков пальцев» , гибридизация) Генетическая инженерия

http: //www. slideshare. net/Fa. To. Oo. Maa/phage-therapy-6802754



СБРОС



http: //www. slideshare. net/jochoa/18 -virus-viroides-y-priones







Лизогенных цикла вирусной ДНК интегрируется в геном хозяина бактерии продолжают нормальных метаболических процессов (репликации ДНК, синтез белка, делением) Вирус остается скрытым, пока срабатывает, чтобы ввести литического цикла 11. Умножение животных, вирусов животных может отличаться от фагов при входе в клетку-хозяина. Вирус отличается в связи с прокариотических и эукариотических клеток. Животное вирусы не могут иметь все ферменты найдены в фаг. Умножение этого вируса разделяют ДНК и РНК, которая содержит вирусов животных.

Структура фага Т 4

Life cycle of a lytic phage

Assay for lytic phage

Circularization of phage chromosome: cohesive ends

Site-specific recombination

Termination of lysogeny

Фаги-?




+


http: //www. slideshare. net/Jolie 11/bacteria-viruses#btn. Last

= Вирусы намного меньше бактерий: . 03 - 0, 30 не может рассматриваться с световой микроскоп состоит из одной молекулы нуклеиновой кислоты, окруженной белковой оболочке молекулы нуклеиновой кислоты могут быть одноили двухцепочечной ДНК или РНК сумму нуклеиновых кислот гораздо меньше, чем бактерии, бактерии имеют достаточно ДНК для 2000 генов многие вирусы имеют только 10 генов, крупнейший составляет около 100 генов 41. Вирусные стратегии вирусные гены несут инструкции для производства новых вирусных частиц Вирусы не имеют рибосомы или других цитоплазматических структур выполнять свои генетические инструкции Вирусы не могут жить самостоятельно, все паразиты живых клеток они используют энергии и белка производство механизмов клетки-хозяина, чтобы сделать новые вирусные частицы

http: //www. slideshare. net/Jolie 11/bacteria-viruses#btn. Last

= Вирусная защита белковой оболочки состоит из нескольких сотен молекул белка упакованы в геометрический узор Некоторые из них имеют комплекс капсулы, окружающей белковой оболочки 43. Вирусные структуры 44. Специфика Каждый тип вируса поражает определенный тип клетки вирусов, поражающих бактерии = бактериофага есть "хвост", который крепится к бактериям 45. Бактериофаг 46. Элементы бактериофагов 47. Репродукция вирусов Два основных жизненных циклов Литические цикла лизогенных цикла Некоторые из них один цикл жизни или другим Некоторые из них могут перейти тип жизненного цикла в зависимости от нагрузки на окружающую среду

http: //www. slideshare. net/Jolie 11/bacteria-viruses#btn. Last

http: //www. slideshare. net/Jolie 11/bacteria-viruses#btn. Last

http: //www. slideshare. net/Jolie 11/bacteria-viruses#btn. Last

Литического цикла Пример E. coli фагом: хвост волокон соответствуют молекулам в принимающих клеточной мембране так специфически связываются только фаг прикрепляется, он действует как шприц - впрыскивает свою ДНК в принимающей Внутри клетки, ДНК фага берет на себя цитоплазматических механизмов клетки-хозяина делает копии ДНК фага 49. Литического цикла (продолжение) рибосомы клетки-хозяина производить белки в соответствии с геном фага инструкции. Новые белки фага и нуклеиновых кислот собрались вместе в клетке и формы несколько сот новых частиц фага ДНК фага поручает клетки-хозяина на самоуничтожение клетки-хозяина делает фермент, который переваривает лизирует или клеточной стенки бактерий Когда лизирует клетки-хозяина, он релизы новых частиц фага 50. Литического цикла фага Т 4

http: //www. slideshare. net/josemanuel 7160/tema-16 -microbiologa

http: //www. slideshare. net/Jolie 11/bacteria-viruses#btn. Last

= Измененный Литические цикла Некоторые вирусы имеют измененные литического цикла Они не лизировать клетки-хозяина, вирус выходит на выталкивание через клеточную мембрану Эти вирусы имеют капсулы, которые состоят частично из принимающих клеточной мембраны и частично вирусного белка Пример: человеческий вирус гриппа 52. Вирусный Задержка Некоторые вирусы могут принять как активных, так и скрытой формах. Во время активной фазы, вирус вмешивается в нормальный метаболизм клетки, вызывая симптомы заболевания во время латентной фазы, это как если бы вирус пошел спать. Несмотря на клетках-хозяевах остаются инфицированными, хозяин бессимптомного носителя заболевания. Разница между активным и скрытые проявления вирусной инфекции от результатов переключатель в вирусную репликацию моделей. Некоторые вирусы могут только повторить по литического пути. Другие вирусы могут ввести свою ДНК в клеткухозяина, но вводили ДНК может быть неактивной, пока соответствующие сотовой событие вызывает ее пробуждении.

http: //www. slideshare. net/Jolie 11/bacteria-viruses#btn. Last

Лизогенных цикла последнем путь называется умеренным или лизогенных пути. После ввода клетку-хозяина, вирусная вставки ДНК в ДНК хозяина в результате рекомбинации ДНК вируса становится частью ДНК хозяина вирусных ДНК не берет на себя клетки-хозяина Когда клетка-хозяин воспроизводит, вирусные гены также дублируется Там может быть никаких активных вирусных частиц, образующихся для поколений спорадически, вирусная ДНК станет активным и триггер воспроизводства 54. Лизогенных цикла (Продолжение) Когда лизогенных вирусной ДНК становится активным, он вырывается из ДНК хозяина литического как она разразится, вирусная ДНК может занять несколько бактериальных генов с этим вирусом могут нести бактериальные гены от предыдущего хозяина к новому хост во время инфекционного цикла этого процесса = трансдукции, используемые в рекомбинантных ДНК исследования можно искусственно вызывать все клетки в культуре лизогенных ввести литическую пути, подвергая их воздействию УФ-светом или рентгеновскими лучами. Пример: Вирус герпеса (вызывает герпес, может вызвать рак

http: //www. slideshare. net/Jolie 11/bacteria-viruses#btn. Last

Открытие лизогенных цикла лизогенных путь был впервые обнаружен в бактериофагов в начале 1920 -х годов это было не совсем понял до 1950 года впервые исследовал на клеточном уровне от Львова Андре, французский ученый. Lwoff знал, что некоторые бактериальные культуры, которые росли нормально, а в противном случае казался совершенно здоровым были инфицированы фага. Несмотря на то, фаг не мешает принимающей бактерий, таких культур была способность вызывать лизис или разрыв другие бактерии. Таким образом, культура была описана как "лизогенных". 56. Раскрытие лизогенных цикла было известно, почему такие культуры были смертельным для других бактерий. Лизогенных эффект не вытекают из фагов частиц, плавающих в культуру культуры остались смертельными даже после удаления любого свободного плавания фага. Эффект был не связано с резервом фага хранится в клетках-хозяевах не фага были освобождены, когда клетки лизогенных культуры были искусственно распахнулась. 57. Львова на Discovery Львова наблюдается рост

Львова на Discovery Львова наблюдается рост бактериальных клеток одного из Bacillus megaterium в крошечные капельки среды. Установлено, что свободные частицы фага и не было найдено плавающим в каплях, которые содержали только отдельные клетки Они были найдены в колонии, полученные из отдельных клеток. Иногда одной ячейки в капле наблюдают спонтанно лопнуть, выпуская около 100 фагов. Заключено, что клетки-хозяева не были полностью застрахованы от фага. Когда фаг стал активным, он вынужден принимающих сделать более фагов, в конце концов убил хозяина, и выпуск новых фагов, когда клетка взрыв. Но, переход от лизогенных к литическим путем были скорее исключением, чем правилом; большую часть времени фаг был в неактивной форме. 58. Фаг Литические и лизогенных Циклы 59. Являются ли вирусы живыми? Вирусы содержат нуклеиновые кислоты и белки вирусов, сами по себе, не может создать или использовать пищу, расти или размножаться Некоторые ученые считают, вирусы не были независимо друг от друга живых организмов Другие полагают, что вирусы эволюционировали от простых бактерий, таких как микоплазмы и риккетсии Другая гипотеза: вирусы генов, которые сбежали из геномы живых клеток не так много доказательств в пользу любой из этих 60. Помимо вирусов Вироиды еще меньше и проще, чем вирусы вызывают некоторые болезни растений короткие отрезки РНК, не белковую оболочку Прионы инфекционные агенты, которые не имеют нуклеиновые кислоты "белок только" BSE

Lysogen From Wikipedia, the free encyclopedia Jump to: navigation, search A lysogen or lysogenic phage is a phage that can exist as a prophage within its host organism. A prophage is the phage DNA in its dormant state, and is either integrated into the host bacteria's chromosome or more rarely exists as a stable plasmid within the host cell. The prophage expresses gene(s) that repress the phage's lytic action, and the phage enters the lytic cycle when this suppression is disrupted. Currently a variety of studies are being conducted to see whether other genes are active during lysogeny, examples of which include phage-encoded t. RNA and virulence genes. Alternatively, lysogen can refer to a strain of bacterium that carries a prophage.

http: //www. slideshare. net/doctorrao/medical-virology-

4-Бактериофаги.ppt